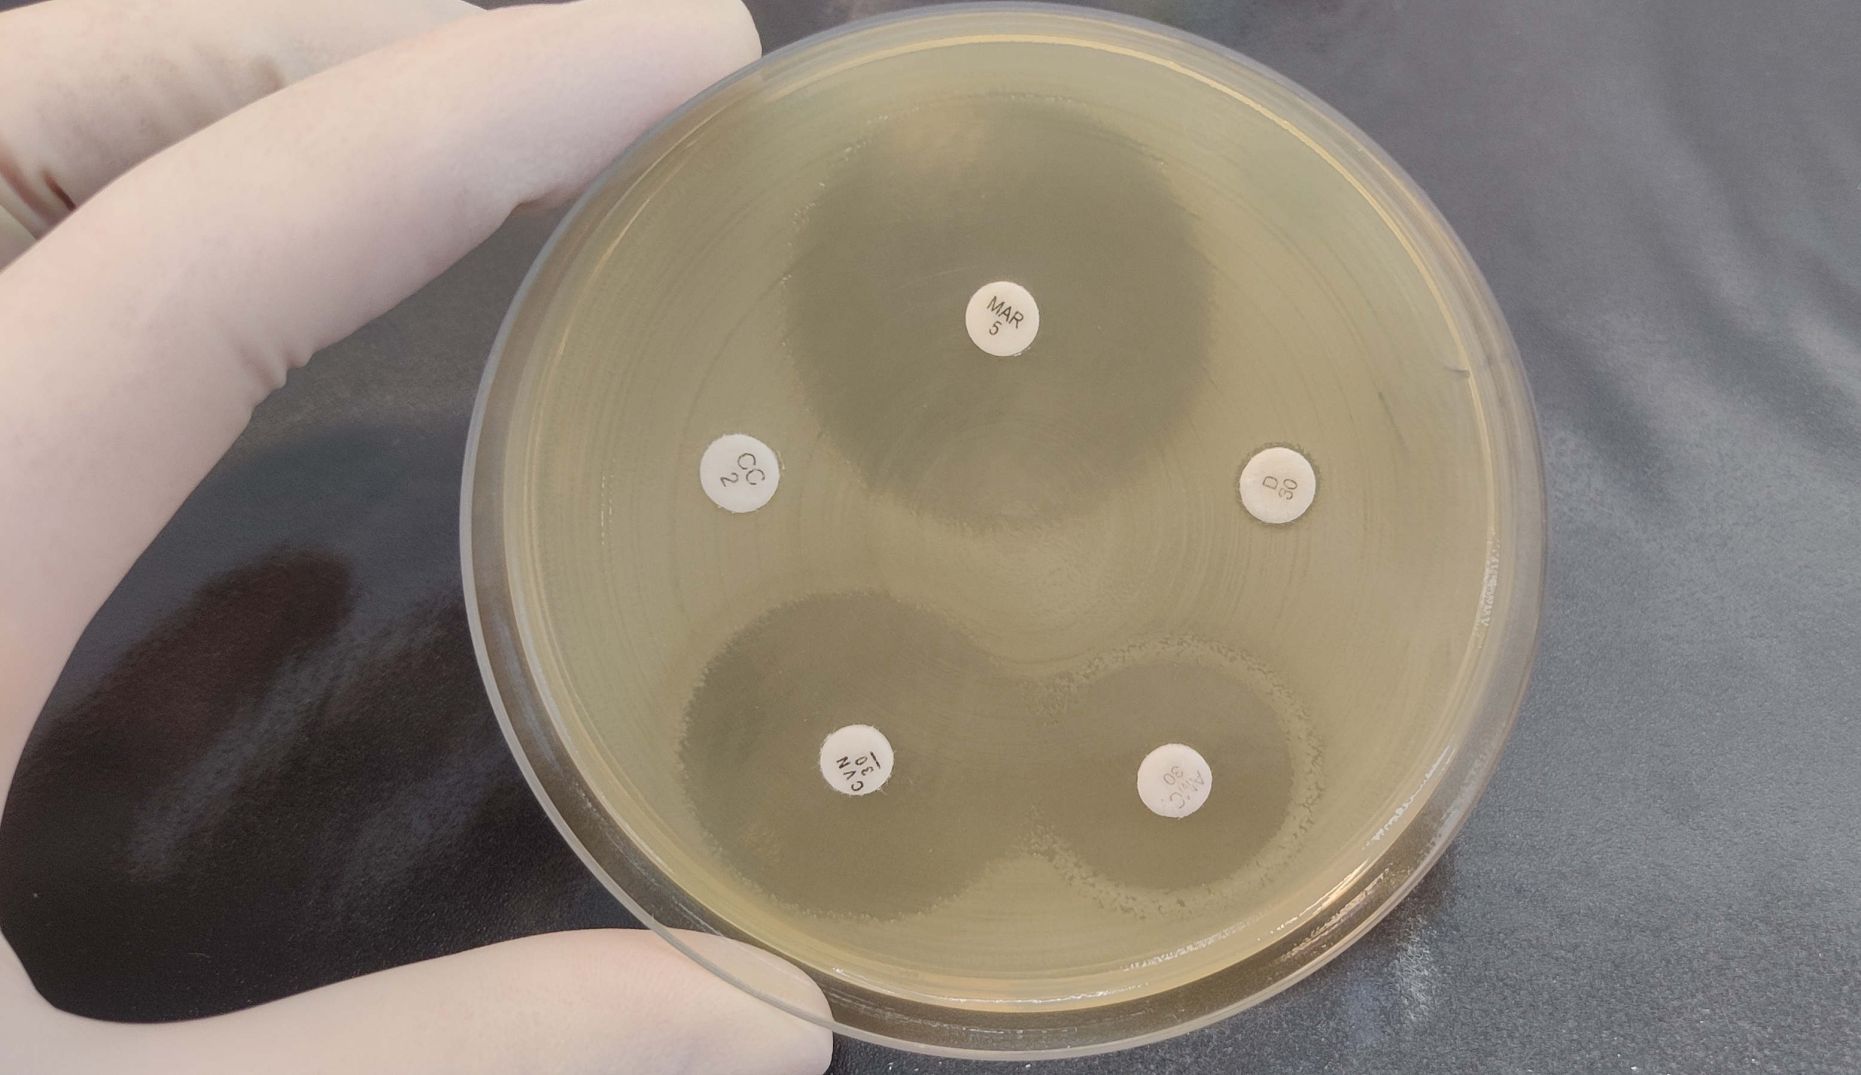
Foto: Antibiogramm naitab antibiootimumide mõju bakteritele

19. novembril toimus Riigi Laboriuuringute ja Riskihindamise Keskuse (LABRIS) eestvedamisel antimikroobse resistentsuse (AMR) teemaline infopäev. Antibiootikumiresistentsust hinnatakse maailmas üheks suuremaks ohuks inimeste ja loomade tervisele. Ravimite vastutustundetu kasutamise tagajärjel võivad mikroobid tulevikus ravimitele enam mitte alluda.
- Tarbimine ja tervis
- 21. november 2025
- Foto: Tartu Ülikooli tehnoloogiainstituudi professor Tanel Tenson infopäeval teadmisi jagamas / Pressifoto
Haiguste Ennetamise ja Tõrje Euroopa Keskuse hinnangul põhjustavad ravimresistentsed nakkused Euroopa Majanduspiirkonnas igal aastal üle 35 000 surma. Haigestumist põhjustavate mikroobide (nii bakterite, seente, parasiitide kui ka viiruste) ravimresistentsuse kasv ohustab kaasaegset meditsiini, muutes keerulisemaks elupäästvad protseduurid, näiteks elundisiirdamised, vähiravi, operatsioonid ja intensiivravi.
Ülemaailmse antimikroobse resistentsuse teadlikkuse nädala raames toimunud sündmuse eesmärk oli jagada teadmisi antibiootikumide ja seenhaiguste ravimite vastasest resistentsusest ning arutada, millised kokkupuutekohad inimesel, loomadel ja keskkonnal AMR-i levikus tegelikult on.
Infopäev tõi selgelt esile vajaduse tõhustada koostööd ning tõsta vastutustundlikku ravimikasutust ja ravimijääkide käitlemist kõikides sektorites. Avakõnes rõhutas seda ka LABRISe asedirektor Mari Reinik, kelle sõnul on antimikroobse resistentsuse ohjamine valdkondadeülene väljakutse, mis nõuab järjepidevat ja sisulist koostööd.
„Varasematel AMR infopäevadel on osalejad korduvalt rõhutanud, et tõhusad lahendused sünnivad just siis, kui inimtervise, veterinaaria ja keskkonna spetsialistid tegutsevad ühiselt, jagavad kogemusi ning hoiavad end ühises infoväljas,“ lisas Reinik.
AMR-i leviku vähendamisel on oluline näha laiemat pilti, sest resistentsus ei tunne valdkondade ega riikide vahelisi piire. Mitmeid toimeaineid kasutatakse nii inimeste, loomade kui ka taimede ravis, mistõttu võivad ravimijäägid liikuda keskkonnas ja toetada resistentsete mikroobide levikut. Esinejate sõnul mõjutavad olukorda ka rahvastiku kasvust tulenev suurenenud toiduvajadus, halvenev keskkonnatervis ja nakkushaiguste laiem levik, mis kõik võivad muuta mikroobide omadusi ja suurendada resistentsuse riski. Probleemi mõistmiseks ja arengute jälgimiseks on vaja süsteemseid uuringuid, sest mitmed AMR-i ülekandeteed on endiselt vaid osaliselt teada.
TÜ Kliinikumi lastekliiniku juhataja Tuuli Metsvaht tõi esile, et pidev valmisolek on hädavajalik ka Eestis:
„Eesti vastsündinute osakondade olukord AMR-i vaates on hetkel hea, aga kindlasti ei tohi me võimalikku ohtu unustada.“
Seda kinnitas ka Eesti Maaülikooli veterinaarmeditsiini ja loomakasvatuse instituudi kaasprofessor Piret Kalmus: „Mikroobide jaoks pole olulist vahet, kas nakatada inimest või looma, mistõttu on inimeste tervise säilitamiseks oluline analüüsida mikroobide "käitumismustreid" nii loomadel, keskkonnas kui inimesel.“
Lisaks eelkõnelejatele said infopäeval sõna veel Regionaal- ja Põllumajandusministeeriumi, Sotsiaalministeeriumi, Terviseameti, Ravimiameti, Maaelu Teadmuskeskuse, Tartu Ülikooli, Tallinna Tehnikaülikooli, Synlabi ja Väikeloomakliiniku NordicVet esindajad.
Antimikroobse resistentsuse levikut aitab vähendada meie kõigi vastutustundlik käitumine:Terv
- Kasuta antibiootikume ainult arsti ettekirjutusel.
- Võta antibiootikumikuur lõpuni, isegi kui enesetunne paraneb.
- Ära kasuta eelmisest ravikuurist alles jäänud ega teistele määratud antibiootikume ja ära jaga enda antibiootikume teistele.
- Vii kasutamata ja aegunud ravimid apteeki või jäätmejaama, kuid kindlasti ära viska neid prügikasti ega kanalisatsiooni, mis võib põhjustada nende sattumist keskkonda.
- Pese regulaarselt käsi ja järgi häid hügieenitavasid, et vähendada nakkuste levikut.
Kui sulle see lugu meeldis, siis toeta sõltumatut rohelist meediat Anneta
